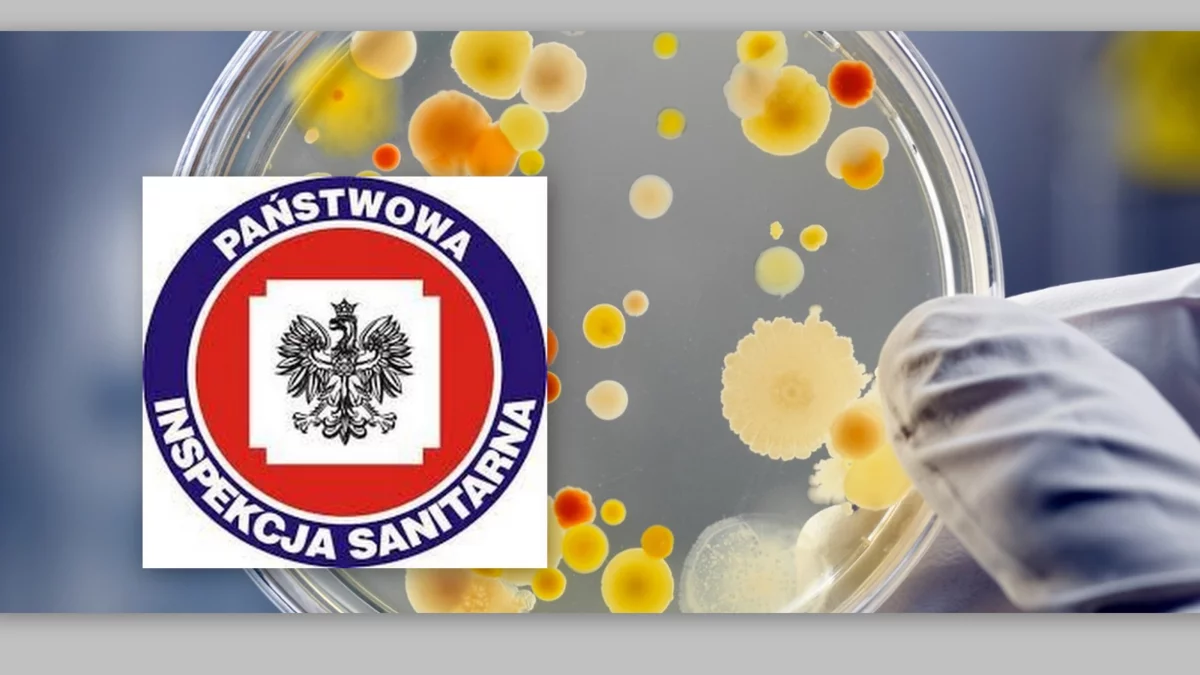

W 2024 r., po uspokojeniu się sytuacji związanej z COVID-19, zauważono wzrost zachorowań na inne choroby zakaźne. Do Powiatowej Stacji Sanitarno-Epidemiologicznej w Łukowie zgłoszono 2 tys. 168 przypadków chorób zakaźnych oraz 22 przypadki gruźlicy.
Nadzór epidemiologiczny Sanepidu opiera się głównie na aktywnym zgłaszaniu przez lekarzy przypadków podejrzenia lub rozpoznania chorób zakaźnych. Jeśli lekarze nie zgłaszają tych przypadków, to dane są niepełne lub zaniżone.
CHOROBY ZAKAŹNE W POWIECIE ŁUKOWSKIM W 2024 R.
GRYPA: 2024 r: 26 przypadków potwierdzonych PCR (w tym 16 dzieci do lat 14); 452 przypadki potwierdzone testem antygenowym;
COVID-19 (SARS-CoV-2): 2024 r.: 636 zachorowań, 2 zgony; (2023 r: 677 zachorowań, 10 zgonów ).
CHOROBY PRZENOSZONE PRZEZ KLESZCZE:
1.Borelioza z Lyme: 2024 r.: 44 przypadki, zapadalność 43,58, hospitalizacje – 3; (w 2023 r.: 41 przypadków, zapadalność 17,18, hospitalizacji – 0);
2.Neuroborelioza: 2024 r.: brak przypadków (również 0 w 2023 r.);
3.Kleszczowe Zapalenie Mózgu (KZM): 2024 r.: 10 przypadków, hospitalizacji – 10; (w 2023 r.: 4 przypadki);
ZAKAŻENIA HIV, ZACHOROWANIA NA AIDS: 2024 r.: 1 przypadek, brak hospitalizacji; (w 2023 r.: brak przypadków);
CHOROBY PRZENOSZONE DROGĄ PŁCIOWĄ: 2024 r.: 1 przypadek zakażenia Chlamydią, brak przypadków kiły; (w 2023 r.: 3 przypadki kiły);
WIRUSOWE ZAPALENIA WĄTROBY (WZW):
WZW typu B: 2024 r.: 1 przypadek, hospitalizacja – 1; (w 2023 r.: 3 przypadki);
WZW typu C: 2024 r.: 9 przypadków, hospitalizacji – 8; (w 2023 r.: 5 przypadków);
WZW typu A: 2024 r.: brak przypadków i hospitalizacji (również brak w 2023 r.).
OGNISKA ZATRUĆ POKARMOWYCH/ZAKAŻEŃ JELITOWYCH:
W 2024 r. nie odnotowano ognisk. (W 2023 r.: 3 ogniska, w tym: 1 domowe (Salmonella Enteritidis),1 w firmie cateringowej (Salmonella Enteritidis),1 w oddziale psychiatrycznym SPZOZ w Łukowie (Clostridium difficile).
CHOROBY ZAKAŹNE PRZEWODU POKARMOWEGO – SALMONELLOZY:
2024 r.: 38 przypadków (w 2023 r.: 55 przypadków)
WIRUSOWE ZAKAŻENIA JELITOWE:
Rotawirus: 2024r .: 78 przypadków (2023 r: 34 przypadki);
Norowirus: 2024 r: 43 przypadki; (2023r.: 14 przypadków)
Adenowirus: 2024 r.: 25 przypadków (2023 r.: 10 przypadków)
NIEOKREŚLONE WIRUSOWE ZAKAŻENIA
2024 r.: 1 przypadek (2023 r: 7 przypadków)
U dzieci do 2 lat: 2024r: 57 przypadków (2023 r.: 15 przypadków); Duży wzrost zakażeń wirusowych jelit u najmłodszych.
GRUŹLICA: 2024 r.: liczba zachorowań na gruźlicę płucną i pozapłucną, w tym dzieci do 18 r.ż. – 22; (2023 r. - 24 przypadki);
WŚCIEKLIZNA/POTRZEBA SZCZEPIEŃ - STYCZNOŚĆ I NARAŻENIE
2024 r.: zakwalifikowano do szczepień – 34 (w 2023 r. -35 osób)

Komentarze (0)
Wysyłając komentarz akceptujesz regulamin serwisu. Zgodnie z art. 24 ust. 1 pkt 3 i 4 ustawy o ochronie danych osobowych, podanie danych jest dobrowolne, Użytkownikowi przysługuje prawo dostępu do treści swoich danych i ich poprawiania. Jak to zrobić dowiesz się w zakładce polityka prywatności.